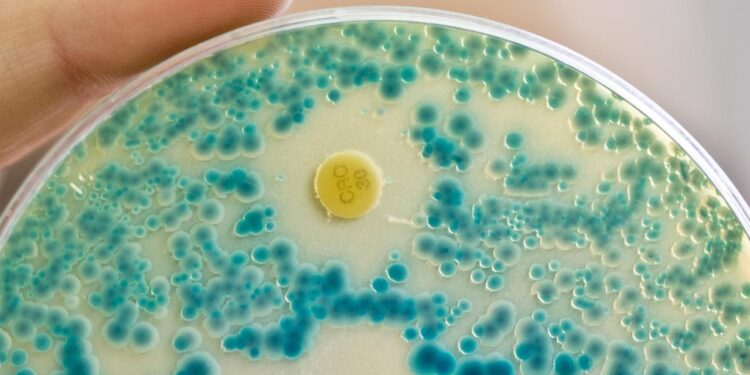
warnung-der-who:-immer-mehr-antibiotika-wirken-nicht-mehr

Stand: 13.10.2025 11:42 Uhr
Die Resistenz vieler Krankheitserreger gegen Antibiotika nimmt weltweit zu. Die WHO warnt, die Antibiotikaresistenz sei schneller als die Fortschritte der modernen Medizin und bedrohe die Gesundheit weltweit.

Weltweit war 2023 jede sechste laborbestätigte bakterielle Infektion resistent gegen Antibiotika, berichtet die Weltgesundheitsorganisation. Das bedeutet: Es wird immer schwieriger, bestimmte Infektionen zu behandeln.
Bedrohung für globale Gesundheit
Im Fokus der Studie war insbesondere die Häufigkeit von Resistenzen bei 22 gebräuchlichen Antibiotika, die bei Harn-, Magen-Darm- oder Blutinfektionen sowie gegen die Geschlechtskrankheit Gonorrhoe (Tripper) zum Einsatz kommen. Die Daten aus mehr als 100 Ländern seien eine Warnung. „Die Antibiotikaresistenz ist schneller als die Fortschritte der modernen Medizin und bedroht die Gesundheit weltweit“, sagt WHO-Generaldirektor Tedros Adhanom Ghebreyesus.
Wettlauf zwischen Bakterien und Antibiotika-Entwicklung
„Das Problem ist, dass wir einen Wettlauf haben zwischen den Krankheitserregern und den Antibiotika, die wir neu entwickeln können“, sagt der Epidemiologe Yvan Hutin, Direktor der zuständigen WHO-Abteilung. Es sei zu beobachten, dass Bakterien diesen Wettlauf gewinnen, indem sie Mutationen entwickelten und sich anpassen.
„Das geschieht schneller als das Tempo, mit dem wir neue Antibiotika herstellen oder entwickeln können“, so Hutin. Die Fähigkeit, Infektionen zu behandeln, gehe verloren. Das sei unter anderem eine große Gefahr für Menschen nach Operationen oder Krebsbehandlungen.
Große regionale Unterschiede
Resistente Krankheitserreger sind überall auf der Welt ein Problem. Am stärksten betroffen aber sind laut WHO ärmere Länder und solche mit schwachen Gesundheitssystemen. So sei die Antibiotikaresistenz in Südostasien und im östlichen Mittelmeerraum am höchsten.
Nach dem neuen Bericht war dort ein Drittel der gemeldeten Infektionen resistent, in Afrika war es jede fünfte. Europa ist weniger stark betroffen – auch aufgrund guter Überwachungs-strategien. Doch die Anstrengungen müssten verstärkt werden, so WHO-Experte Hutin, „um sicherzustellen, dass wir für Patienten, die ins Krankenhaus eingeliefert werden, weiterhin wirksame Antibiotika zur Verfügung haben.“
„Eines der wichtigsten Ergebnisse des Berichts ist, dass die Länder, die am wenigsten in der Lage sind, Antibiotikaresistenzen zu diagnostizieren, auch diejenigen sind, die die höchste Belastung melden“, sagt WHO-Experte Hutin. „Diesen blinden Fleck können wir uns nicht leisten.“ Alle Länder müssten dringend ihre Kapazitäten zur Diagnose antimikrobieller Resistenzen stärken und umfassende Überwachungssysteme aufbauen, damit ausreichend Daten für Risikobewertung und Risikomanagement zur Verfügung stehen.
Millionen Todesfälle weltweit
Nach WHO-Angaben sind allein im Jahr 2021 7,7 Millionen Menschen weltweit an einer bakteriellen Infektion gestorben. Dabei seien mehr als eine Million Todesfälle direkt auf Antibiotikaresistenzen zurückzuführen gewesen. In Deutschland sind nach Schätzungen des Robert-Koch-Instituts im Jahr 2019 fast 10.000 Menschen an einem resistenten Krankheitserreger gestorben.
Verlässliche Prognosen für die Zukunft seien schwierig, sagt Yvan Hutin. „Aber wir machen uns große Sorgen, weil wir sehen, dass das Tempo, mit dem bestimmte Krankheitserreger resistent werden steigt und schneller wird als unsere Fähigkeit, neue Antibiotika zu entwickeln.“ Ohne vermehrte Investitionen in Überwachung und Forschung, so warnt die WHO, könnten wichtige Antibiotika bis 2035 gänzlich an Wirksamkeit verlieren.